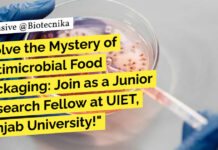
Panjab University Research Fellow

Home 2024
Yearly Archives: 2024
Cipla Vacancies For BSc Microbiology – Apply Online
Cipla Vacancies For BSc Microbiology - Apply Online
Junior Team Member - Microbiology
Posting Date: 22 Jul 2024
Country: India
State: Goa
Location: Goa
Req Id: 86328
Job Purpose
Execute analysis of...
Merck India Quality Control Specialist Role For Biotech & Microbiology – Apply Online
Merck India QC Vacancies For Biotech & Microbiology - Apply Online
Quality Control Specialist
Bangalore, Karnataka, India
Job Type: Full-time
Work Your Magic with us!
Ready to explore, break...
Biotecnika Times Newsletter 22.07.2024 – CSIR NET June 2024 Admit Card Download, Paid Internships...
Download CSIR NET June 2024 Exam Admit Card
Download your CSIR NET June admit card now.
Paid Student Internship at IARI - Apply Now!
Apply for the...
Exclusive 2-Month Student Internship at NIPER! Apply Now!
2-Month Student Internship at NIPER! Apply Now!
Employment Notification No: NIPER/HJP/PA/SERB/SRG/2024-25/01
Date: 18.07.2024
The National Institute of Pharmaceutical Education and Research (NIPER) is the first Institute...
Paid Student Internship at IARI – Apply Now!
Paid Student Internship at IARI - Apply Now!
DIVISION OF ENTOMOLOGY
Indian Agricultural Research Institute, Pusa, New Delhi 110012
Student internship positions for a period of two...
Project Associate Position in Biotechnology at Amity University – Apply Now!
Project Associate Position at Amity University - Apply Now!
Advertisement Date: 18.07.2024
Amity University Uttar Pradesh, Noida invites applications for
Amity Institute of Biotechnology (AIB)
for Project Associate
Name...
Apply Now for Senior Research Associate Position at Syngene – Life Science Eligible
Syngene Research Associate Molecular Biology, Apply Online Now
Title: Senior Research Associate Molecular Biology
Date: 22 Jul 2024
Job Location: Bangalore
Pay Grade: 9-II
Year of Experience: 0 -...
Zoological Survey of India Life Sciences Project Fellow Recruitment – Apply Now
ZSI Zoology Project Fellow - Applications Invited
Government of India
Ministry of Environment, Forests and Climate Change
ZOOLOGICAL SURVEY OF INDIA
Advt. No. ZSI-GOK/MNPSCS/02/24
ADVERTISEMENT FOR SENIOR PROJECT FELLOW
Candidates...
AIIMS Delhi Non-Medical SRF Job For Biochemistry & Biotechnology, Applications Invited
AIIMS Non-Medical SRF Vacancy For Biochemistry & Biotechnology, Applications Invited
Advertisement for the post of SRF in a DHR-funded project
Subject: Recruitment for the post of...
CSIR-CFTRI MSc, BTech Life Science, Microbiology & Biochemistry Project Recruitment – Apply Online
CFTRI Mysuru Project Recruitment - Life Sciences, Biochem, Microbiology Apply Online
CFTRI Mysuru Project Recruitment - Life Sciences, Biochem, Microbiology Apply Online. Interested and eligible...
Panjab University Biotech & Life Sciences Research Fellow Recruitment – Applications Invited
Panjab University Research Fellow Recruitment - Biotech & Life Sciences Apply
UNIVERSITY INSTITUTE OF ENGINEERING AND TECHNOLOGY PANJAB UNIVERSITY, CHANDIGARH – 160014, INDIA
(Estt. under the...
Register Now! FREE Webinar by MP Biomedicals on NGS – Optimizing Techniques
Free Biotecnika Webinars NGS - Optimizing Techniques - Registrations Open
Next Generation Sequencing - Optimizing Techniques
Join MP Biomedicals for an insightful webinar focusing on "Next Generation...
Exciting Job Opportunity at ICMR-NIRRCH- BSc, MSc Biotech & Life Sciences Apply Now!
ICMR-NIRRCH Biotech Project Jobs - Life Sciences Apply Online
ICMR-National Institute for Research in Reproductive and Child Health
Indian Council of Medical Research
Jehangir Merwanji Street, Parel,...
Executive QA Job at iD Fresh Food! BSc Food Science, Food Tech Apply
Executive QA Vacancy at iD Fresh Food! BSc Food Science, Food Tech Apply
Executive - Supplier Quality Assurance
Anekal, Karnataka, India
About the job
About iD Fresh Food...
Download CSIR NET June 2024 Exam Admit Card
CSIR NET June Admit Card Download - CSIR NET Admit Cards Download Link
PUBLIC NOTICE
21.07.2024
RELEASE OF ADMIT CARDS FOR
JOINT CSIR-UGC NET EXAMINATION JULY, 2024
National Testing...